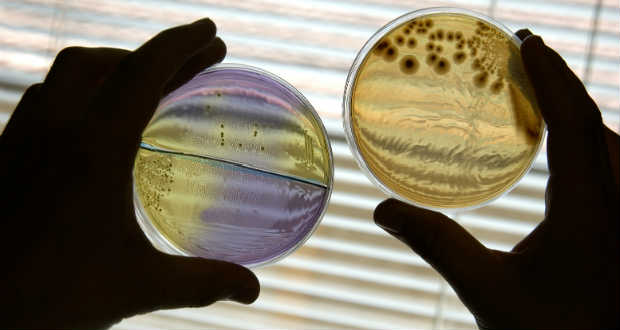
Reggelente „veszélyesebbek” a vírusok

Kárpátaljai magyar és ruszin gyermekek táboroznak Ópusztaszeren
Kárpátaljai magyar és ruszin gyermekek táboroznak Ópusztaszeren – erről beszélt az Emberi Erőforrások Minisztériumának nemzetiségi és civil társadalmi kapcsolatokért felelős helyettes államtitkára az M1 aktuális csatorna szerda reggeli műsorában.